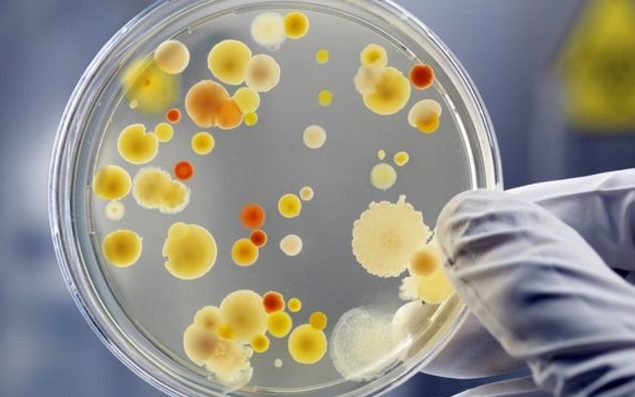

El pinzamiento de cadera es una causa frecuente de dolor de cadera/ingle en personas jóvenes y es una de las causas frecuentes de artrosis precoz. La causa del pinzamiento está en la forma del fémur, del acetábulo (parte de la pelvis que recibe a la cabeza femoral) o ambos. La anormalidad de forma causa un choque entre estos 2 al mover la cadera lo que genera dolor, daño al labrum, posiblemente al cartílago, y en el largo plazo puede causar artrosis.
No todos los pacientes con pinzamiento requieren cirugía, en caso de requerirlo, esta es posible de realizar mediante artroscopia. En 2018 la revista Lancet (una de las más importantes revistas en medicina) publicó un trabajo donde se mostró que la cirugía artroscópica es mejor que la kinesiterapia y manejo no quirúgico como tratamiento para el pinzamiento de cadera.